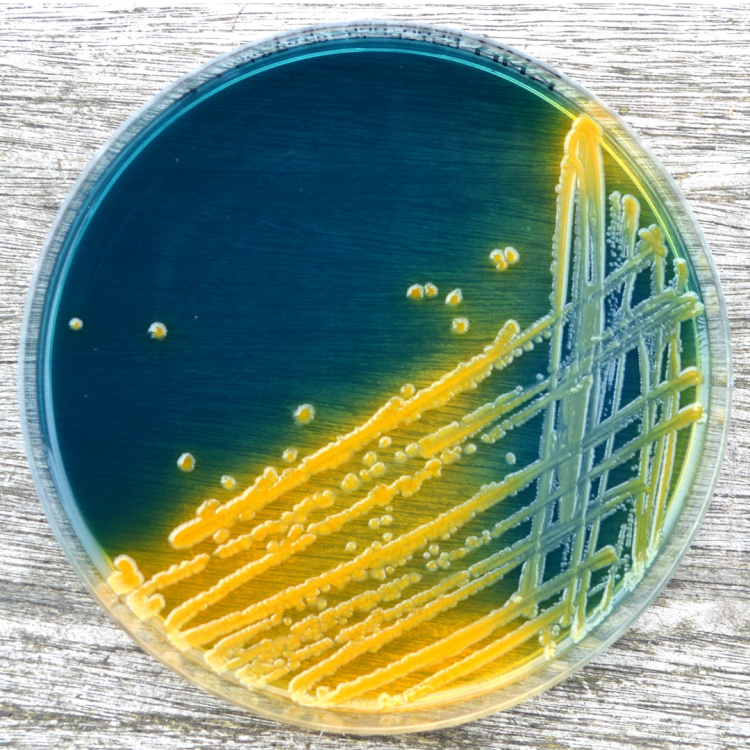

Ariangela J. Kozik, PhD
Microbiologist. Computational Biologist. Science Communicator. Advocate.
Dr. Kozik earned a BS in Biotechnology from Calvin College before obtaining her PhD in Comparative Pathobiology at Purdue University. She completed Postdoctoral study at the University of Michigan Medical School, and also received additional post-graduate training in Personalized and Genomic Medicine from the University of Colorado-Anschutz.
Enthusiasm for the human microbiome and its potential contributions to health and disease influenced a desire to seek training in translational research. Her research experiences have spanned multiple facets of microbiology. She conducted undergraduate research on phage diversity and graduate research on the gut microbiome in Inflammatory Bowel Disease. She received an NIH NRSA Postdoctoral Fellowship at the University of Michigan where she studied the relationship between the respiratory microbiome and asthma heterogeneity. As a Research Investigator in Pulmonary and Critical Care Medicine at the University of Michigan, she continued her work on microbial-immune relationships in adult asthma, with emphasis on precision approaches for asthma treatment. In her current role as Assistant Professor, her laboratory works at the intersection of microbiology, immunology, and bioinformatics, leveraging multi-omic strategies to interrogate host-microbe and microbe-microbe crosstalk in interkingdom relationships in the airway.
Dr. Kozik believes that increasing public engagement with science and the scientific process is critical to a just society, and her science communication efforts have included audiences from elementary school students to adults. Her commitment to the next generation of scientists is evident through her advocacy and service work. Dr. Kozik is Co-Founder and Vice President of the Black Microbiologists Association (BMA, also Black In Microbiology), serves on the Health Equity and Diversity Committee of the American Thoracic Society, and also promotes research on the reciprocal impact of social inequality and microbiomes through her work with the Microbes and Social Equity Working Group.
Features
https://asm.org/Press-Releases/2022/August-2022/ASM-Selects-Honorees-for-Prestigious-Awards
https://crosstalk.cell.com/blog/1000-inspiring-black-scientists-in-america